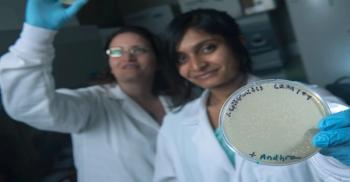

News




New research on why the influenza vaccine was only modestly effective in recent years shows that immune history with the flu influences a person's response to the vaccine.

\Nonprofit organization Aeras announced results from an innovative clinical trial that provides encouraging new evidence that TB vaccines could prevent sustained infections in high-risk adolescents.

Measles has rebounded in the World Health Organization (WHO) European Region.

The genetic cause behind a strain of typhoid's resistance to five classes of antibiotics has been uncovered by scientists at the Wellcome Sanger Institute and their collaborators at Public Health England and Aga Khan University, Pakistan.

A new study by scientists at the Gladstone Institutes shows that infection sites could affect the immune system's response to a virus and the way the virus spreads through the body.

A review by Birgand, et al. (2018) provides an analysis of governance approaches within healthcare systems including: priority setting, performance monitoring and accountability for AMR prevention in three European countries: England, France and Germany.


A team of USC Viterbi School of Engineering researchers has created an algorithm that can help policymakers reduce the overall spread of disease.

Researchers have discovered crucial new processes that allow malaria parasites to escape red blood cells and infect other cells, offering potential new treatment targets.

Bacteria-killing viruses could be employed not just in healthcare, but also in the food industry, a study conducted at the University of Helsinki indicates.

Researchers at the University of Illinois at Chicago will conduct a study to determine how the use of menstrual cups helps prevent vaginal infections and sexually transmitted infections.


With a new $15 million grant, scientists at the Scripps Research Institute (TSRI) are gearing up for an in-depth study of survivors of viral outbreaks.

A new blood test called the Tick-Borne Disease Serochip (TBD Serochip) promises to revolutionize the diagnosis of tickborne disease by offering a single test to identify and distinguish between Borrelia burgdorferi and seven other tickborne pathogens.

Flannery and Chung, et al. (2018) report that so far this season, influenza A(H3N2) viruses have predominated, but other influenza viruses are also circulating.

According to a new study, screening all adults for hepatitis C (HCV) is a cost-effective way to improve clinical outcomes of HCV and identify more infected people compared to current recommendations.

Researchers at La Jolla Institute for Allergy and Immunology have identified a subset of T cells, whose frequency serves as early childhood immune signature that predicts the risk of developing asthma later on.

Anyone who has had chickenpox or the chickenpox vaccine is at risk for shingles.

Researchers at the University of Illinois at Chicago have now identified a small drug molecule that can clear the HSV-1 infection in the cells of the cornea and works completely differently than the currently-available drugs, making it a promising potential option for patients who have developed resistance.

New diagnostic methods and treatments – including fecal transplantation – will help improve the care of patients with Clostridium difficile (C. diff.), a deadly bacterial infection that can occur after antibiotic use, according to updated guidelines released by the Infectious Diseases Society of America (IDSA) and Society for Healthcare Epidemiology of America (SHEA) and published in the journal Clinical Infectious Diseases.

Queen’s University Belfast is playing a central role in an international consortium that has announced the development of a patch delivery system which will lower the chances of infection for those at very high risk of HIV.

Freedman, et al. (2018) reviewed documented coccidioidomycosis outbreaks from the period 1945–2015 to identify common features and prevention opportunities.


Material scientists at the University of Manchester, working in collaboration with universities in China, have created a 'durable and washable, concrete-like' composite material made from antibacterial copper nanoparticles.

A new study published in the Journal of Immunology offers new insights as to why healthy children are much more vulnerable to influenza.

Budd, et al. (2018) report in MMWR that influenza activity in the United States began to increase in early November 2017 and rose sharply from December through Feb. 3, 2018; elevated influenza activity is expected to continue for several more weeks.